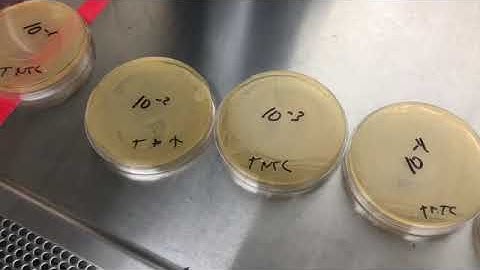
Lab 7 (Part 6 of 6) Calibration Graph and Serial Dilution 1

⬇ DOWNLOAD NOW
Kalau muncul iklan pop-up, tutup lalu klik tombol kembali
Download lagu Lab 7 (Part 1 of 6) Calibration Graph and Serial Dilution secara gratis hanya untuk keperluan promosi. Dukung artis favorit kamu dengan membeli musik original di iTunes atau platform resmi lainnya.
Lab 7 (Part 6 of 6) Calibration Graph and Serial Dilution 1
Lab 7 (Part 6 of 6) Calibration Graph and Serial Dilution 1
 Lab 7 (Part 2 of 6) Calibration Graph & Serial Dilution
Lab 7 (Part 2 of 6) Calibration Graph & Serial Dilution
 Lab 7 (Part 3 of 6) Calibration Graph and Serial Dilution
Lab 7 (Part 3 of 6) Calibration Graph and Serial Dilution
 Lab 7 (Part 4 of 6) Calibration Graph and Serial Dilution
Lab 7 (Part 4 of 6) Calibration Graph and Serial Dilution
 Lab 7 (Part 5 of 6) Calibration Graph and Serial Dilution
Lab 7 (Part 5 of 6) Calibration Graph and Serial Dilution
 How to prepare a Serial Dilution
How to prepare a Serial Dilution
 ONE-STAGE ASSAY OF FACTOR VIII (FVIII) – LAB MANUAL: VIDEO 3
ONE-STAGE ASSAY OF FACTOR VIII (FVIII) – LAB MANUAL: VIDEO 3
 Practical techniques 1: Mic calibration and serial dilution
Practical techniques 1: Mic calibration and serial dilution